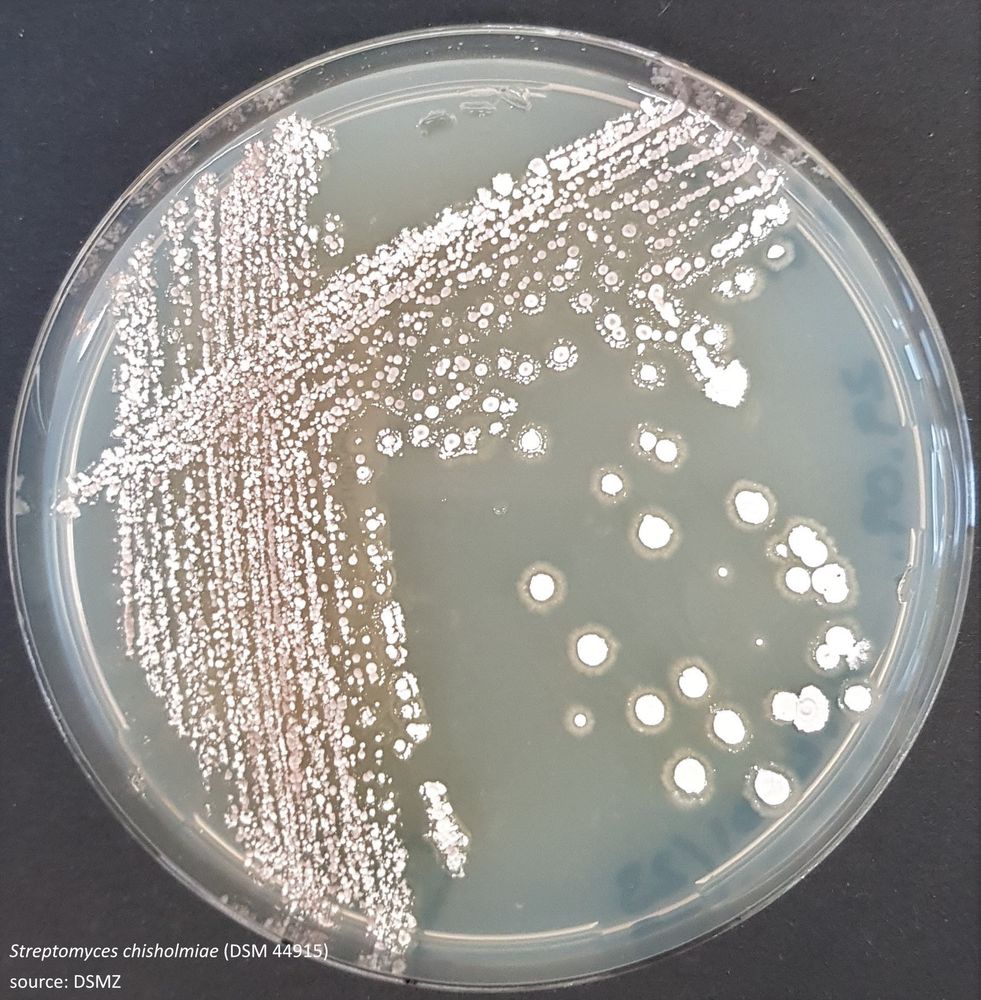

Angélique Gobet
@agobet.bsky.social
240 followers
230 following
5 posts
Microbial ecologist working on bacteria and algae using omics approaches @ MARBEC joint research unit https://umr-marbec.fr/en/
Board member of the French Phycological Society societephycologiquedefrance.fr/en/
Tutor of the HosMic program hosmic.uth.gr
Posts
Media
Videos
Starter Packs
Reposted by Angélique Gobet
Reposted by Angélique Gobet
Reposted by Angélique Gobet
Angélique Gobet
@agobet.bsky.social
· Apr 18

Offre de thèse : « LE RÔLE DU MODE TROPHIQUE DANS LA CROISSANCE DES MICROALGUES MARINES SUR LES EFFLUENTS DE FERMENTATION DE LA BIOMASSE »
Thesis proposal: "THE ROLE OF THE TROPHIC MODE IN THE GROWTH OF MARINE MICROALGAE ON BIOMASS FERMENTATION EFFLUENTS" École doctorale : GAIA
umr-marbec.fr
Angélique Gobet
@agobet.bsky.social
· Apr 18

New PhD thesis opportunity at MARBEC!
The role of the trophic mode in… | Angélique Gobet
New PhD thesis opportunity at MARBEC!
The role of the trophic mode in the growth of marine microalgae on biomass fermentation effluents
More information here:
https://lnkd.in/eK5xTzqg
Application ...
www.linkedin.com
Reposted by Angélique Gobet
Reposted by Angélique Gobet
Tillmann Lueders
@luederslab.bsky.social
· Mar 19

FEMS Summer School for Postdocs 2025 - FEMS
Menu: Introduction – Applications – Programme This has been the most valuable and enjoyable scientific event I’ve attended so far. The atmosphere was incredible, with inspiring co-directors and mentor...
fems-microbiology.org
Reposted by Angélique Gobet
Reposted by Angélique Gobet
Reposted by Angélique Gobet
Reposted by Angélique Gobet
Reposted by Angélique Gobet
Reposted by Angélique Gobet
Reposted by Angélique Gobet
Reposted by Angélique Gobet
Angélique Gobet
@agobet.bsky.social
· Feb 16
Reposted by Angélique Gobet
Reposted by Angélique Gobet
Reposted by Angélique Gobet
Reposted by Angélique Gobet
Reposted by Angélique Gobet
Emil Ruff
@emilruff.bsky.social
· Dec 18

A global comparison of surface and subsurface microbiomes reveals large-scale biodiversity gradients, and a marine-terrestrial divide
The microbiomes of Earth’s surface and subsurface environments are different in composition, but similar in diversity.
www.science.org
Reposted by Angélique Gobet
Reposted by Angélique Gobet